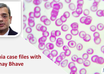
anaemia

Anaemia case files with Dr. Abhay Bhave
M3 India Newsdesk | Aug 28, 2019
American Academy of Otolaryngology–Head and Neck Surgery Foundation guideline for Tonsillectomy in children
M3 India Newsdesk | Aug 27, 2019
Virtual Tumour Board: Multidisciplinary panel discusses case of 42-year old patient with early breast cancer
M3 India Newsdesk | Aug 27, 2019
Differential diagnosis of Dementia; what to look for in baseline investigations?: Dr. Prithika Chary
M3 India Newsdesk | Aug 26, 2019
Hyperuricaemia in hypertension: A villain or an innocent bystander? Dr. Tiwaskar
M3 India Newsdesk | Aug 25, 2019
5 international destinations no doctor should miss
M3 Global Newsdesk | Aug 24, 2019
Insight 46 study urges those with high BP to treat it regardless of age: The Lancet
M3 India Newsdesk | Aug 23, 2019
Government introducing incentives for doctors, but concerns still remain
M3 India Newsdesk | Aug 23, 2019
Novel drug targets could change treatment landscape for NSCLC patients
M3 Global Newsdesk | Aug 22, 2019
Is it viral or bacterial? Evidence-based disease management & case discussions by Dr. Balaji Chinnaswami
M3 India Newsdesk | Aug 22, 2019
Most read this week